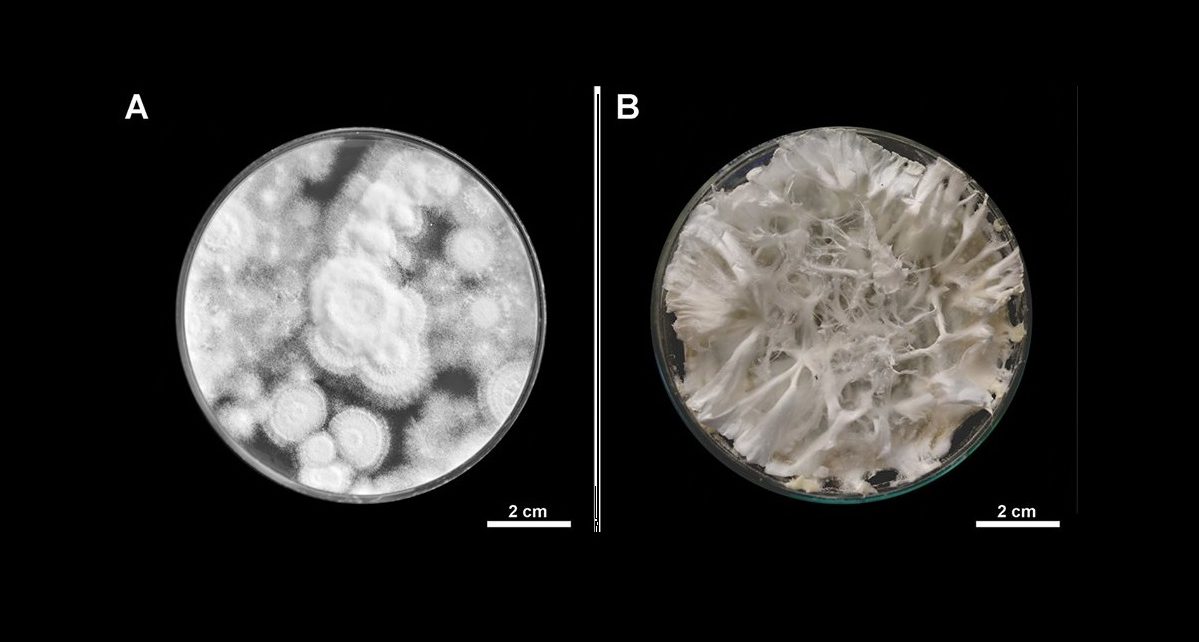

(Lima, 12 de septiembre del 2019).- Científicos de la Universidad Nacional Toribio Rodríguez de Mendoza de Amazonas (UNTRM), lograron identificar un nuevo hongo con propiedades biológicas adecuadas para controlar la plaga de la broca del café, dentro de un proyecto de investigación financiado por el Instituto Nacional de Innovación Agraria (INIA) del Ministerio de Agricultura y Riego.
Se trata del hongo entomopatógeno Beauveria peruviensis que, por su especificidad e inocuidad es un arma importante, pues al ser un controlador biológico permite evitar el uso de insecticidas y productos químicos en el cultivo del café y ayuda a preservar el medio ambiente.
Esta variedad de hongo fue localizado en el distrito de Huambo, provincia de Rodríguez de Mendoza, región Amazonas.
“Es una especie nueva para el mundo científico y una contribución fundamental que hace el sector a través del INIA, que está dándole un fuerte impulso a la investigación y al desarrollo de tecnología para la producción agraria, promoviendo además la incorporación de investigadores jóvenes”, señaló Jorge Maicelo, jefe del INIA.
Este descubrimiento marca un hito internacional y contribuirá de manera eficiente a solucionar un problema fitosanitario, que ha venido afectado al café orgánico, uno de nuestros principales productos que agroexportación.
La ejecución del proyecto fue financiado por el INIA a través del Programa Nacional de Innovación Agraria (PNIA), y desarrollado por un equipo de científicos de la UNTRM.